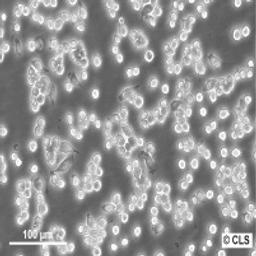
RAW 264.7 - Cell Lines Service GmbH - Life Sciences

RAW 264.7
Murine Leukemia macrophage cell line. Frozen cryovial. 4 Mio. cells/ml.

The supplier does not provide quotations for this product through SelectScience. You can search for similar products in our Product Directory.
Biosafety level: L2
Murine Leukemia macrophage cell line
Organism: Mus musculus (mouse)
Strain: BALB/c
Gender: Male
Tissue: Ascites
Celltype: Macrophage
Growth Properties: Monolayer, adherent
Description: The RAW 264.7 cell line was established from a tumor induced by the Abelson murine leukemia virus. The cells will pinocytose neutral red and will phagocytose latex beads and zymosan. They are capable of antibody dependent lysis of sheep erythrocytes and tumor cell targets. LPS or PPD treatment for 2 days stimulates lysis of erythrocytes but not tumor cell targets. The cells do not produce detectable retrovirus.